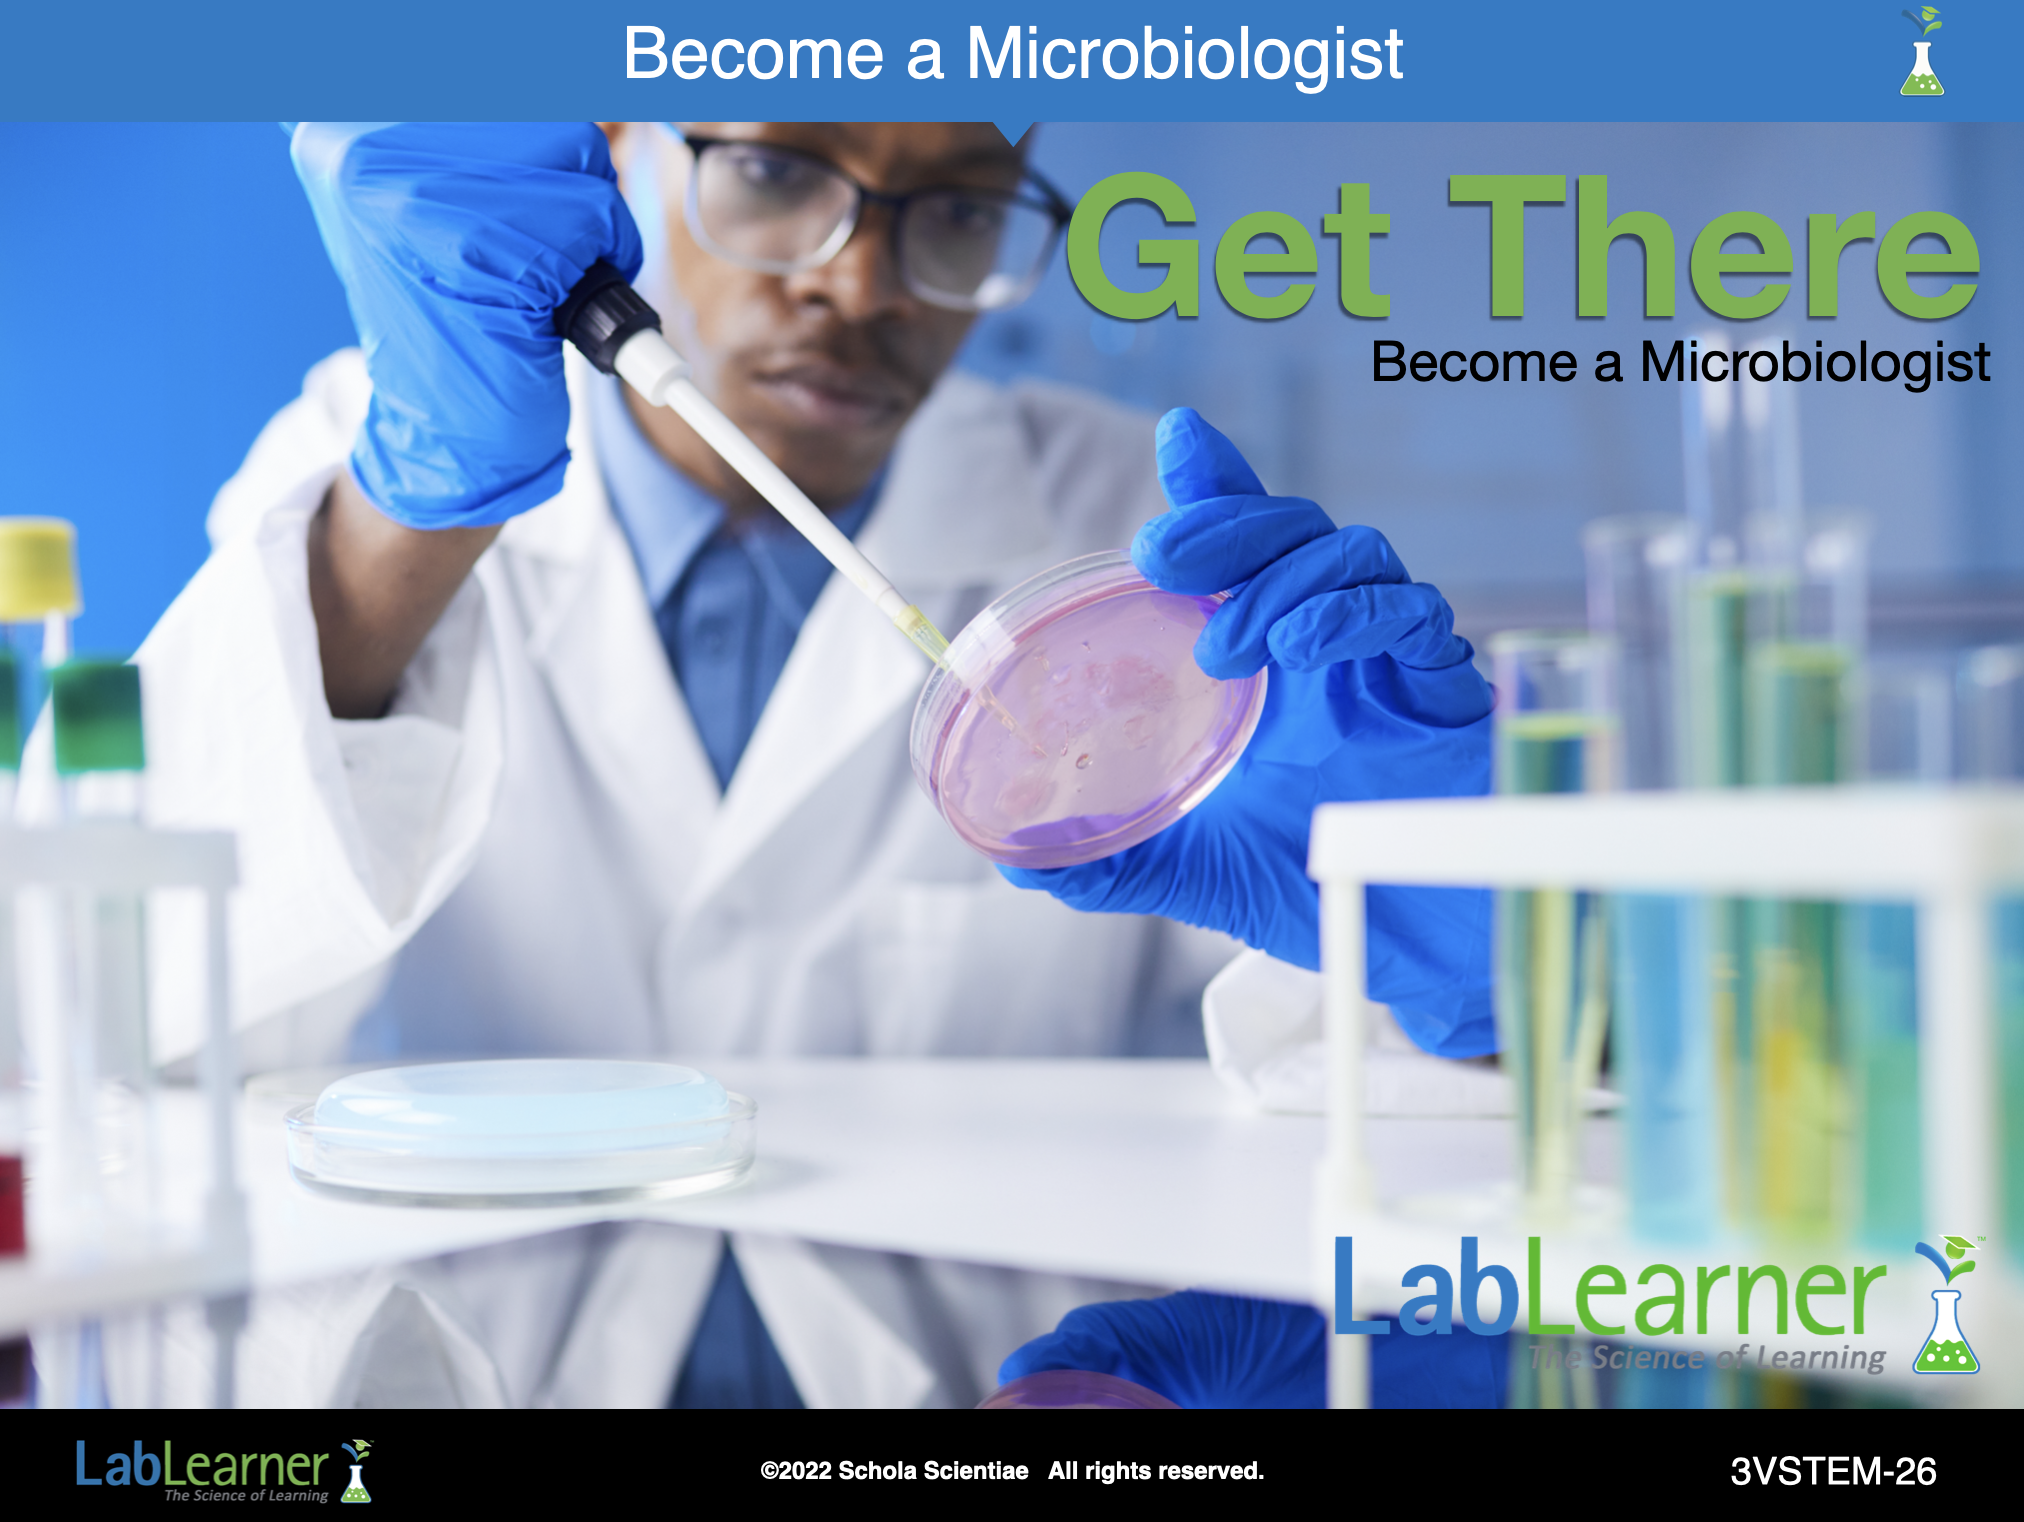

Teacher Portal
A STEM Career for You?
PRINT IT
Use your browser to download a printable PDF as help during the slide presentation and to make additional notes. In your browser, go to File > Print and then choose to save as PDF.
NAVIGATE IT
Once the slide presentation is launched
- use your left and right arrows to advance or go back in the slide presentation, and
- hover your mouse over the left edge of the presentation to get a view of the thumbnails for all the slides so that you can quickly move anywhere in the presentation.
- Click HERE to launch the slide presentation for the CELL.
SHARE IT

SLIDE 3VSTEM-1
There are so many different directions that we can go in the world. We begin by learning how to talk and walk and play. Next, we go to school to learn to read, write, and do mathematics. We go through elementary school, then middle school, and finally high school. But what happens next?
For most of our lives, we will work and earn a living through our work. That is, you will be paid to do your work. Our life’s work and our careers can be among the most rewarding, enjoyable, and satisfying parts of our lives. In this third Lesson of the LabLearner STEM Careers Journey, students will be exposed to a wide variety of important STEM fields and the careers they offer.
______________________________________________

SLIDE 3VSTEM-2
You may be surprised to know that many students already start thinking about their career path well before graduating high school. If one decides to attend college, such a decision is typically made during high school and even before high school graduation you likely will know what college you will attend and perhaps even the classes you will take when you first get there. From this point on, many of the classes you take will begin the training for your future career.
______________________________________________

SLIDE 3VSTEM-3
Therefore, it is never too early to start thinking about what you may wish to do to earn a living someday. Even though you are free to change your mind along the way, you will begin heading in one direction or another once you leave high school.
So, let’s stop for a moment and ask ourselves a question that many generations of students have had to ask before you – “What do I want to do for a living, what do I want to be when I grow up?”
Ask students: Which career do you think you will pursue? Allow students to share ideas with the class.
______________________________________________

SLIDE 3VSTEM-4
If you answer the question – What do I want to be when I grow up? – that you want to be a professional athlete, you may still attend college and play for a college team. When not playing your sport or practicing it, you will take classes and plan on a career either instead of going into professional sports or after retiring from professional sports.
If you truly want to be a pro athlete – a baseball player, for example – you may well already be gaining some of the basic skills, knowledge, and practice that will help you many years from now. Little League today… the Detroit Tigers or New York Yankees tomorrow!
______________________________________________

SLIDE 3VSTEM-5
The same applies to other careers, such as music, art, writing, and many others. Even though you may ultimately play an instrument or sing, paint, draw, or write short stories or poems for a living, there is still a good chance that some of your training will come in the form of college classes and perhaps a college degree.
Although college and a career may seem a long way off from middle or high school, many students begin preparing for their eventual careers even when they have many years before graduation. Let’s say you want to be a musician someday; you may join the school orchestra or even start a rock band!
______________________________________________

SLIDE 3VSTEM-6
Similarly, if you want to be an artist someday and make a living creating and selling your art, you likely already enjoy drawing or painting. You can take art classes at your school or in your community. You may even enter your creations into a competition… or sell them!
Therefore, you should always pay close attention to what you are doing and learning right now, but keep a clear eye on where you wish to be, in terms of a career, when you are an adult.
______________________________________________

SLIDE 3VSTEM-7
But what about STEM careers? What are they, and how can you prepare yourself for them? To answer these questions and begin the fascinating and rewarding path that STEM careers offer, consider the following tasks.
You should:
- Know what STEM careers are available to you.
- Know which skills are required for the STEM careers you think you might be interested in.
- Know which pre-college classes will help prepare you for a STEM career.
The remainder of this LabLearner STEM Careers Journey is designed to help you gain knowledge to make good decisions and prepare your way for an exciting career in a STEM profession. So let’s begin by considering what STEM careers are available.
______________________________________________

SLIDE 3VSTEM-8
STEM career categories: Computer and Information Sciences
National Center for Education Statistics, U.S. Department of Education
There are enormous career opportunities in STEM fields. In the next several slides, you will see a list of some of the STEM fields currently identified by the National Center for Education Statistics at the U.S. Department of Education.
As we go through this long list, consider that many STEM fields of the future have yet to be identified! That is, there will undoubtedly be many additional STEM fields and careers added to this list as new advances in science, technology, engineering, and mathematics take place in the coming years. By the time you reach adulthood, this list will even be longer!
To organize the list, the STEM careers are grouped into several categories:
- Computer and Information Sciences
- Engineering and Engineering Technologies
- Biological and Biomedical Sciences
- Mathematics and Statistics
- Physical Sciences
Note to Teacher: The intent of this and the following 11 slides is not to go through each of the careers listed but rather impress upon students the sheer magnitude of the STEM field and the number of choices available.
______________________________________________

SLIDE 3VSTEM-9
STEM career categories: Engineering and Engineering Technologies
National Center for Education Statistics, U.S. Department of Education
______________________________________________

SLIDE 3VSTEM-10
STEM career categories: Engineering and Engineering Technologies (Continued)
National Center for Education Statistics, U.S. Department of Education
Note to Teacher: As you go through the STEM careers list, you may wish to select one or two careers from each category and discuss them briefly with the class. For example:
Ask students: What do you think a ____________ does for a living? What does their job entail? Why is it important?
Ask students: Do you know anyone who is a _______________?
______________________________________________

SLIDE 3VSTEM-11
STEM career categories: Engineering and Engineering Technologies (Continued)
National Center for Education Statistics, U.S. Department of Education
______________________________________________

SLIDE 3VSTEM-12
STEM career categories: Engineering and Engineering Technologies (Continued)
National Center for Education Statistics, U.S. Department of Education
______________________________________________

SLIDE 3VSTEM-13
STEM career categories: Engineering and Engineering Technologies (Continued)
National Center for Education Statistics, U.S. Department of Education
______________________________________________

SLIDE 3VSTEM-14
STEM career categories: Biological and Biomedical Sciences
National Center for Education Statistics, U.S. Department of Education
It is important to note that for many, perhaps even most, of the STEM fields, a range of educational preparation may be involved. For example, on this slide, a career in Molecular Biochemistry or Wildlife Biology may require a Doctorate (~8 years+ of college) for certain jobs in the field. On the other hand, one can prepare for a job as a lab technician or wildlife officer, or manager with a Bachelor’s degree (~4 years of college) or a Master’s degree (Bachelor’s plus ~2 additional years of college).
This range of college preparation for a job in a STEM field is a general rule for most STEM careers.
______________________________________________

SLIDE 3VSTEM-15
STEM career categories: Biological and Biomedical Sciences (Continued)
National Center for Education Statistics, U.S. Department of Education
Ask students: What value do these professions bring to our world today? Student answers will vary. Some may suggest the need for medical research and innovation in light of the recent COVID-19 pandemic, chronic disease, and illness.
______________________________________________

SLIDE 3VSTEM-16
STEM career categories: Mathematics and Statistics
National Center for Education Statistics, U.S. Department of Education
While there are specific careers in the Mathematics and Statistics category, it is important to note that the subject of mathematics is a prerequisite for most other STEM careers. Many STEM college programs and degrees require a substantial amount of mathematics courses.
Interestingly, a serious focus in middle school and particularly in high school mathematics courses can lead to a fast track once arriving at college. For example, most STEM fields require mathematics courses, at least through calculus. A firm grounding in algebra and geometry in middle school/high school will overcome the need for remedial college courses in these subjects. In addition, many high schools offer courses in calculus. Thus, if it is available and practical, learning calculus mathematics in high school may save you time (and tuition) in college!
______________________________________________

SLIDE 3VSTEM-17
STEM career categories: Physical Sciences
National Center for Education Statistics, U.S. Department of Education
Ask students: Have you ever seen a meteorologist? Student answers will vary. Actually, many of the weathermen and women on television are meteorologists.
______________________________________________

SLIDE 3VSTEM-18
STEM career categories: Physical Sciences (Continued)
National Center for Education Statistics, U.S. Department of Education
______________________________________________

SLIDE 3VSTEM-19
STEM career categories: Physical Sciences (Continued)
National Center for Education Statistics, U.S. Department of Education
______________________________________________

SLIDE 3VSTEM-20
What Biochemists Do: Biochemists and biophysicists study the chemical and physical principles of living things and of biological processes.
Work Environment: Biochemists and biophysicists typically work in laboratories and offices to conduct experiments and analyze the results. Most work full-time.
How to Become a Biochemist: Biochemists and biophysicists need a Ph.D. to work in independent research and development. Many Ph.D. holders begin their careers in temporary postdoctoral research positions. Bachelor’s and master’s degree holders qualify for some entry-level positions in biochemistry and biophysics.
Applicable LabLearner CELLs: While essentially all LabLearner CELLs are important for a sound fundemental grounding in gscience, the CELLs highlighted in RED STAR below are particularly relevant to a aspiring biochemist:
Important academic subjects for high school: Chemistry, Biology, Physics, Mathematics, and writing classes.
______________________________________________

SLIDE 3VSTEM-21
What Astronomers Do: Astronomers study stars, planets, moons, comets, asteroids, and other celestial bodies.
Work Environment: Astronomers may work in offices, research laboratories, and observatories. Most astronomers work full-time, and some work more than 40 hours per week.
How to Become an Astronomer: Astronomers typically need a Ph.D. for jobs in research and academia.
Applicable LabLearner CELLs:
Important Academic Subjects for High School: Physics, Mathematics, Chemistry, Computer Science, and writing classes.
______________________________________________

SLIDE 3VSTEM-22
What physicians and surgeons do: Physicians and surgeons diagnose and treat injuries or illnesses and address health maintenance.
Work environment: Physicians and surgeons work in both clinical and non-clinical settings. Clinical settings include physicians’ offices and hospitals; nonclinical settings include government agencies, nonprofit organizations, and insurance companies.
How to Become a Physician or Surgeon: Physicians and surgeons typically need a bachelor’s degree and a medical degree, which takes another 4 years to complete. Depending on their specialty, they also need 3 to 9 years in internship and residency programs. Sub-specialization includes additional training in a fellowship of 1 to 3 years.
Applicable LabLearner CELLs:
Important academic subjects for high school: Biology, Chemistry, Physics, Mathematics
______________________________________________

SLIDE 3VSTEM-23
What Veterinarians do: Veterinarians care for the health of animals and work to protect public health.
Work Environment: Most veterinarians work in private clinics and hospitals. Others travel to farms or work in laboratories, classrooms, or zoos.
How to Become a Veterinarian: Veterinarians must have a Doctor of Veterinary Medicine degree from an accredited veterinary college, as well as a state license.
Applicable LabLearner CELLs:
Important academic subjects for high school: Biology, Chemistry, Physics, Mathematics
______________________________________________

SLIDE 3VSTEM-24
What Chemists Do: Chemists study substances at the atomic and molecular levels and analyze the ways in which the substances interact with one another.
Work Environment: Chemists work in laboratories and offices. They typically work full-time and keep regular hours.
How to Become a Chemist: Chemists need at least a bachelor’s degree in chemistry or a related field. However, a master’s degree or Ph.D. is needed for many research jobs.
Applicable LabLearner CELLs:
Important academic subjects for high school: Chemistry, Biology, Physics, Mathematics, Computer Science, and writing classes
______________________________________________

SLIDE 3VSTEM-25
What Geoscientist do: Geoscientists study the physical aspects of the Earth.
Work Environment: Geoscientists usually split their time between working in an office setting, in laboratories, and outdoors. Most geoscientists work full-time, and some work more than 40 hours per week. Schedules vary to include irregular hours when doing fieldwork.
How to Become a Geoscientist: Geoscientists typically need a bachelor’s degree to enter the occupation. For some positions, employers prefer hiring candidates with a master’s degree. Most geoscientists need a state-issued license.
Applicable LabLearner CELLs:
Important academic subjects for high school: Physics, Biology, Chemistry, Mathematics, and writing classes
______________________________________________
SLIDE 3VSTEM-26
What Microbiologists do: Microbiologists study microorganisms such as bacteria, viruses, algae, fungi, and some types of parasites.
Work Environment: Microbiologists work in laboratories and offices, where they conduct scientific experiments and analyze the results. Most microbiologists work full time and keep regular hours.
How to Become a Microbiologist: Microbiologists typically need a bachelor’s degree in microbiology or a related field for entry-level jobs. They typically need a Ph.D. to work in research or in colleges and universities.
Applicable LabLearner CELLs:
Important academic subjects for high school: Biology, Chemistry, Mathematics, and writing classes
______________________________________________

SLIDE 3VSTEM-27
What Computer Programmers Do: Computer programmers write, modify, and test code and scripts that allow computer software and applications to function properly.
Work Environment: Programmers usually work in office settings, most commonly in the computer systems design and related services industry. Most computer programmers work full-time.
How to Become a Computer Programmer: Computer programmers typically need a bachelor’s degree to enter the occupation. Most programmers specialize in several programming languages.
Applicable LabLearner CELLs:
Important academic subjects for high school: Computer Science, Mathematics
______________________________________________

SLIDE 3VSTEM-28
What Information Research Scientist Do: Computer and information research scientists design innovative uses for new and existing computing technology.
Work Environment: Most computer and information research scientists work full time.
How to Become an Information Research Scientist: Computer and information research scientists typically need at least a master’s degree in computer science or a related field. In the federal government, a bachelor’s degree may be sufficient for some jobs.
Applicable LabLearner CELLs:
Important academic subjects for high school: Computer Science, Mathematics, Physics
______________________________________________

SLIDE 3VSTEM-29
What Mathematicians and Statisticians Do: Mathematicians and statisticians analyze data and apply computational techniques to solve problems.
Work Environment: The top employers of mathematicians and statisticians are the federal government and scientific research and development companies. Mathematicians and statisticians may work on teams with engineers, scientists, and other specialists.
How to Become a Mathematician or Statistician: Mathematicians and statisticians typically need at least a master’s degree in mathematics or statistics. However, some positions are available to those with a bachelor’s degree.
Applicable LabLearner CELLs:
Important academic subjects for high school: Computer Science, Mathematics, Physics, Calculus
______________________________________________

SLIDE 3VSTEM-30
What STEM Teachers Do: STEM teachers teach academic lessons and various skills that students will need to attend college and enter the job market.
Work Environment: STEM teachers work in schools. They work during school hours but may also work evenings and weekends to prepare lessons and grade papers. Most do not teach during the summer.
How to Become a STEM Teacher: STEM teachers typically have at least a bachelor’s degree. In addition, teachers must have a state-issued certification or license, which may require an academic background in the subject(s) they will be certified to teach.
Applicable LabLearner CELLs:
Note: You may notice that each and every LabLearner CELL and Journey is considered applicable for STEM Teachers. This is because STEM Teachers are responsible for preparing their students for any of the STEM careers that we have discussed. Therefore, STEM Teachers must have a broad and complete range of knowledge and skills in each of the LabLearner CELLs.
Important academic subjects for high school: Earth Science, Mathematics, Physics, Biology, Chemistry
Ask students: Can you identify a common thread necessary for STEM career preparations? Student answers will vary, however be sure to impress upon them that all preparations begin NOW. We do not learn concepts in isolation. Every subject area provides unique perspective and necessary skills to be successful in any career they choose. Careful study and continued diligence will pave the way to success.
______________________________________________








